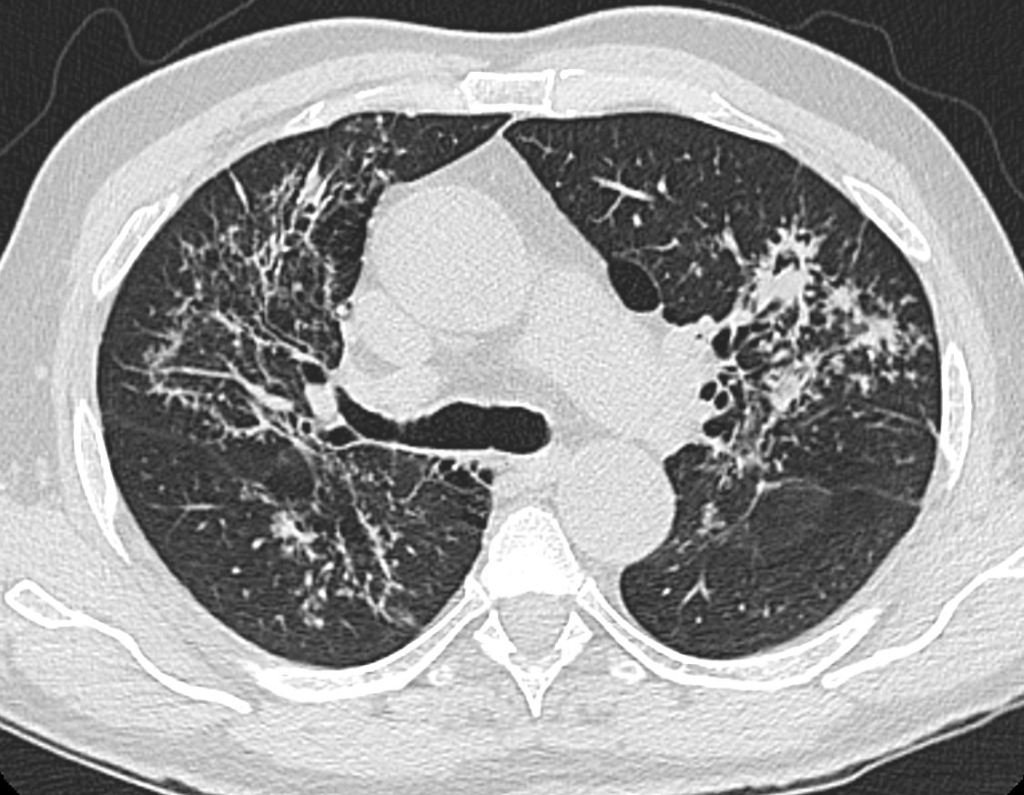
La imagen tiene un atributo ALT vacío; su nombre de archivo es galaxia.jpg
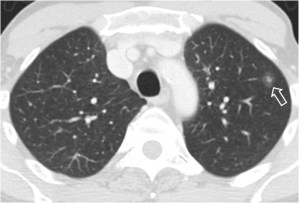
HALO

SIGNO DEL HALO
Es un signo visible en la TC correspondiente a una zona de atenuación intermedia -vidrio deslustrado- alrededor de uno o más nódulos pulmonares. Se trata de un signo no específico por lo que puede verse en muchas enfermedades y se debe a la presencia de hemorragia y necrosis perinodular. Está descrito en la aspergilosis, mucormicosis, candidiasis, tumores muy vascularizados (angiosarcoma, sarcoma de Kaposi), metástasis hipervasculares (riñón, corocarcinoma), infecciones virales (citomegalovirus, herpes simplex), tuberculomas y granulomatosis de Wegener.
En el quiste hidatídico, se ha descrito un halo denso visible en TC y Resonancia causado por infiltrado inflamatorio, reacción alérgica o atelectasia.
La imagen corresponde a un paciente con granulomatosis de Wegener.
Otro ejemplo del signo del halo (flecha).
Este magnífico ejemplo de signo del halo corresponde a un paciente con metástasis de angiosarcoma. Mi agradecimiento a la sección de radiología tórax de mi hospital (Dra. Maribel Padín y Dra. M. Carmen Aguilar) y a Kiko Padilla, que hizo una lectura perfecta del caso.
Aquí van un par de referencias:
Primack SL et al. Pulmonary nodules and the CT halo sign. Radiology 1994; 190: 513-515.
Pinto, PS. The CT halo sign. Radiology 2004; 230: 109-110.
SIGNO DE LA MELLADURA DE RIGLER
La presencia de una melladura o escotadura en el contorno de un nódulo pulmonar solitario se describió como un signo de malignidad. Si bien es cierto que es más frecuentemente visto en nódulos malignos, este signo puede verse también en lesiones benignas, por lo que no resulta útil. En la imagen vemos una escotadura (flecha) en un cáncer de pulmón.
No debe confundirse el signo de la melladura de Rigler con el signo de Rigler o de la doble pared, presente en radiografías de abdomen y TC en pacientes con neumoperitoneo.
SIGNO DE LA COLA PLEURAL o APÉNDICE PLEURO-PULMONAR
Imagen visible en la radiografía de tórax y en la TC que consiste en una banda radiodensa (flecha blanca) que desde un nódulo pulmonar (flecha roja) se extiende hasta la superficie pleural, en donde a menudo existe un engrosamiento focal. Este signo, descrito inicialmente como signo de malignidad, no es 100 % específico.
La imagen corresponde a un paciente con carcinoma epidermoide de pulmón.
Un ejemplo del signo (flecha blanca) en otro paciente, también con carcinoma de pulmón (flecha roja). Existe un derrame pleural derecho asociado.
SIGNO DEL MENISCO AÉREO O CRECIENTE AÉREO Y SIGNO DE MONOD
El signo del creciente aéreo es un signo de aspergilosis angioinvasiva, semiinvasiva y otros procesos que causan necrosis pulmonar. Es visible en la radiografía de tórax o la TC. En la aspergilosis se produce la invasión por hifas de un vaso pulmonar, provocando hemorragia, trombosis y necrosis de una zona del parénquima. Con el tiempo, el tejido infartado que ocupa el centro de la lesión se retrae, y el tejido periférico se reabsorbe, quedando una cavidad con una zona nodular rodeada por una semiluna de aire.
El signo de Monod se refiere a la semiluna aérea que queda en una cavidad que ha sido secundariamente sobreinfectada por hongos, con frecuencia del género Aspergillus, pero también Mucor. Semiológicamente las imágenes son similares y se han confundido. La diferencia está en que la aspergilosis angioinvasiva se ve en pacientes inmunocomprometidos mientras que el aspergiloma que sobreinfecta una cavidad preformada puede verse en pacientes inmunocompetentes.
Más información en el artículo de Abramson S. The air crescent sign. Radiology 2001; 218: 230-232. Se encuentra en el siguiente enlace: http://pubs.rsna.org/doi/full/10.1148/radiology.218.1.r01ja19230.
A la izquierda, el signo de Monod en la TC. A la derecha, al colocar al paciente en decúbito prono se comprueba que la imagen nodular cae a la zona declive y la semiluna aérea queda arriba. Se trata de un aspergiloma.
Otro caso del Signo de creciente aéreo que me envían desde Guatemala los Dres. Ilder Augusto Alvarado Recinos y Carlos Roberto Escobar, médicos residentes del postgrado de Radiología e imágenes diagnósticas del Instituto Guatemalteco de Seguridad Social (IGSS). Mi agradecimiento por su aportación.
SIGNO DE LA SUELTA DE GLOBOS
La presencia de múltiples nódulos pulmonares bien definidos de distribución bilateral y aleatoria, de diferentes tamaños, es muy sugerente de metástasis pulmonares. El nombre del signo es muy gráfico.
El caso que mostramos corresponde a un paciente con metástasis de seminoma. Abajo, la imagen de TC del mismo paciente.
SIGNO DEL CAMALOTE O NENUFAR O LIRIO FLOTANTE
Signo de quiste hidatídico roto, visible en la radiografía de tórax y en la TC. Al romperse el quiste, penetra aire en la cavidad del mismo, creándose un nivel hidroaéreo sobre el que flotan estructuras desprendidas del endoquiste, como vesículas hijas o membranas hidatídicas.
Otro signo de quiste hidatídico complicado es el Signo de la piel de cebolla (onion peel sign o cumbo sign). Consiste en la apariencia de una lámina de aire que penetra entre las capas endoquística y periquística. No tenemos imagen de este signo.
SIGNO DE LA GALAXIA Y SIGNO DEL CÚMULO SARCOIDEO
Se trata de dos signos de sarcoidosis visibles en la TC de tórax, en ventana de parénquima. El signo de la galaxia consiste en un nódulo mayor de un centímetro rodeado de pequeños nódulos satélites. El nódulo central está formado por granulomas confluentes y los pequeños nódulos periféricos son granulomas no confluentes. En la imagen superior vemos nódulos de distribución peribroncovascular y pueden verse nódulos de mayor tamaño rodeados por otros satélites de menor tamaño.
El signo del cúmulo sarcoideo corresponde a nodulillos centrolobulillares de muy pequeño tamaño, próximos pero no confluentes, formando un grupo o acúmulo en la periferia del pulmón que presenta una apariencia que recuerda a los cúmulos de estrellas.
A diferencia del signo de la galaxia sarcoidea, no hay un nódulo central de mayor tamaño. En la imagen se muestra este signo.
Un par de referencias: Large Coalescent Parenchymal Nodules in Pulmonary Sarcoidosis: “Sarcoid Galaxy” Sign.
http://www.ajronline.org/doi/abs/10.2214/ajr.178.6.1781389
I. Herráez Ortega, N. Alonso Orcajo, L. López González. El cúmulo sarcoideo. Un nuevo signo en tomografía computarizada de tórax de alta resolución. Radiología 2009.
http://www.elsevier.es/en-revista-radiologia-119-articulo-el-cumulo-sarcoideo-un-nuevo-13142172